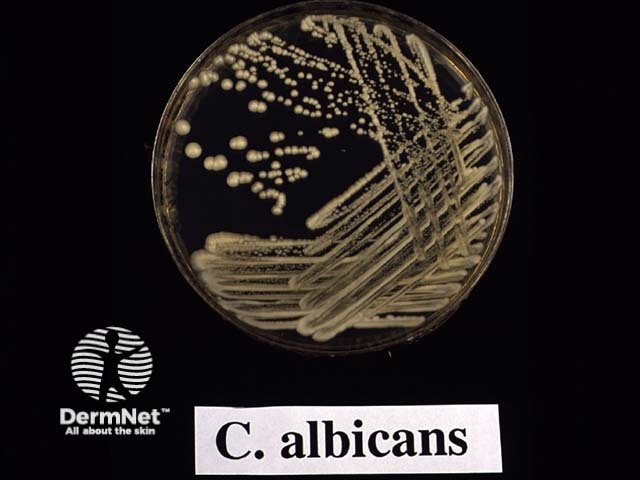
Candida albicans: microscopy and culture

Main menu
Common skin conditions
NEWS
Join DermNet PRO
Read more
Quick links
Created 2009.
Candida albicans is a normal inhabitant of the human digestive tract from early infancy. Opportunistic infection with C. albicans and other Candida species (tropicalis, parapsilosis, glabrata, guilliermondii) is most likely to affect mucosae but sometimes involves skin, and rarely causes systemic disease.
Predisposing factors for infection include:
Characteristically candida causes red and white patches on mucosal surfaces. In skin folds it results in moist fissuring with satellite superficial papulopustules.
Microscopy and culture of smears, blue-top skin swabs and scrapings aid in the diagnosis of candidiasis. However, candida can live on a mucosal surface quite harmlessly. It may also secondarily colonise an underlying skin disorder such as psoriasis; thus positive culture does not always mean a dermatosis is candidiasis.
Infection is confirmed by the presence of yeast cells, which may be dividing by budding, and pseudohyphae (branched filaments similar to those of a dermatophyte) forming a pseudomycelium. Specific sensitivity testing can be done on request.
Candida albicans: microscopy and culture Candida albicans: microscopy and culture
Candida is a commensal organism in 50% of healthy mouths. Oral candidiasis (thrush) indicates invasion of the mucosa by the yeast because of favourable conditions (dentures, smokers, antibiotics, steroid inhalers) or debility. Several clinical subtypes of infection are recognised:

Angular cheilitis

Oral candidiasis
Treatment of oral candidiasis is usually with oral nystatin drops or pastilles, or miconazole gel. Occasionally, oral fluconazole is necessary for severe or persistent disease.
Chronic candidiasis may be pre-malignant or confused with in-situ malignancy. Refer treatment-failures to a dermatologist or oral surgeon for diagnosis and, if necessary, biopsy.
Candidiasis is particularly likely to affect flexures in warm weather especially in those who are obese. Look for mild to moderately irritating bright red plaques, skin-fold fissures, satellite spots and peeling. Specific sites for intertrigo include:


Erosio interdigitalis

Napkin dermatitis: candidiasis
Topical therapy is usually adequate, using miconazole or clotrimazole cream. Dusting powder and antiperspirants such as 3B cream can be useful prophylactically.
Vaginal Candida albicans can be cultured in about 10% of asymptomatic non-pregnant women aged 15 to 55 years. Invasive vaginal candidiasis causes a heavy white curd-like vaginal discharge, a burning sensation in the vagina and vulva and/or erythema and oedema of the labia minora/majora and sometimes extending to adjacent flexures. It is frequently precipitated or aggravated by sexual intercourse.

Candidal vulvovaginitis

Candidal vulvovaginitis
Although swabs can be useful in confirming diagnosis and identifying other infections, borderline or negative culture can be misleading. Non-albicans candida are fairly resistant to treatment.
Straightforward cases are treated with intravaginal pessaries and where required, topical antifungal creams. Subsidised preparations in New Zealand (April 2005) are clotrimazole 500mg single dose, or 100mg x 6 pessaries, and vaginal cream 1% or 2%; and miconazole vaginal cream 2%. It is wise to prescribe an optional repeat prescription.
Cyclic vulvovaginitis refers to recurrent thrush or thrush-like symptoms related to the menstrual cycle. There is often associated dermatitis due to rubbing (lichen simplex) and contact irritants (soaps, detergents, antifungals and many others). Underlying diseases such as diabetes and immunodeficiencies are uncommon but should be ruled out with appropriate blood tests and treated appropriately if present.
These patients require careful examination as other vulval diseases such as condylomata, lichen sclerosus, and vulval intraepithelial neoplasia may be present. Vulvodynia (burning discomfort) should be distinguished from pruritus vulvae and can be a sign of non-albicans yeast or another disease such as erosive lichen planus.
Cyclic vulvovaginitis should be treated in consultation with a dermatologist, gynaecologist or sexual health physician. Mild topical steroids such as hydrocortisone cream are often combined with intermittent oral fluconazole.
Balanitis may be due to candida, bacterial infections, and contact with irritants including soap, smegma, and applied preparations. It is nearly always seen in uncircumcised men and may complicate diabetes.
First line treatment may be with a mild topical steroid/antifungal/antibacterial such as Viaderm KC. Advise the patient to wash the glans with warm water alone and dry carefully and gently before replacing the foreskin.
In cases of persistent balanitis:
Acute staphylococcal paronychia develops over a few hours and may be accompanied by fever and lymphadenopathy. Distinguish this from chronic paronychia, which is most often due to candida species. It starts in a single nail fold then often spreads to several others, later involving the nail plate. It is most likely to affect those whose fingers are cold and wet such as gardeners, fishermen and dairy farmers. Signs include:
Swabs and nail clippings are frequently negative as the nail plate may be injured rather than primarily infected and pus is not always present. Gram negative bacterial infection may be isolated and may coexist with candida.
Management should include:
Subsidised preparations include clotrimazole solution and ciclopiroxolamine nail solution. Persistent severe cases may benefit from intermittent or continuous oral fluconazole, as recommended by a dermatologist.

Chronic paronychia

Onycholysis

Proximal onchomycosis
Nail plate infection or onychomycosis due to candidiasis can follow chronic paronychia but it can rarely occur in its absence. Most often, candida results in onycholysis (lifting of the nail plate from the nail bed) but there are many other causes of onycholysis that may be clinically indistinguishable.
The relevance of a positive candida culture can be uncertain as it may arise in nail dystrophy due to psoriasis or ageing (in which case, antifungal agents result in no improvement). The patient is often best to consult a dermatologist for advice.
Search for evidence to support the use of yogurt to treat or prevent recurrent candidiasis.
Information for patients
See the DermNet bookstore.